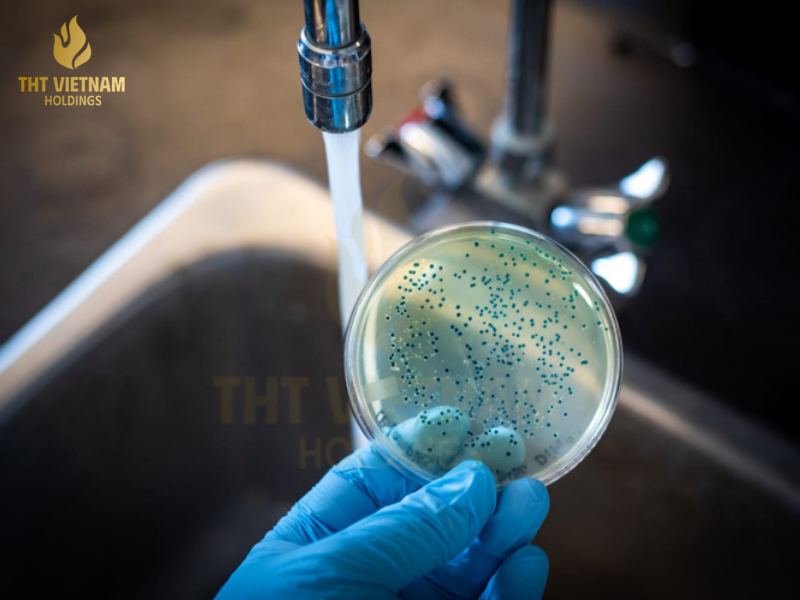

Góc Chuyên Gia - Hoá Mỹ Phẩm
Posted on 21/04/2026 by THT Việt Nam Creator
TOP 10 TIÊU CHUẨN KIỂM ĐỊNH QUAN TRỌNG TRONG NGÀNH HÓA MỸ PHẨM
Trong thế giới hiện đại, khi mà sức khỏe và sự an toàn được đặt lên hàng đầu, ngành hóa mỹ phẩm không còn đơn thuần là cuộc đua về mùi hương hay giá cả. Đó là cuộc đua của chất lượng và sự minh bạch. Bạn có bao giờ tự hỏi, tại sao một […]
Trong thế giới hiện đại, khi mà sức khỏe và sự an toàn được đặt lên hàng đầu, ngành hóa mỹ phẩm không còn đơn thuần là cuộc đua về mùi hương hay giá cả. Đó là cuộc đua của chất lượng và sự minh bạch. Bạn có bao giờ tự hỏi, tại sao một chai nước giặt có thể bảo vệ làn da bé yêu, hay một dung dịch tẩy rửa lại không làm ăn mòn mặt kính đắt tiền?

Câu trả lời nằm ở hệ thống tiêu chuẩn kiểm định khắt khe mà mỗi sản phẩm phải vượt qua trước khi đến tay người dùng. Hãy cùng THT Việt Nam điểm danh 10 tiêu chuẩn vàng giúp định nghĩa một sản phẩm chất lượng trong ngành hóa mỹ phẩm hiện nay.
=> Xem thêm: Xu hướng sản phẩm tiêu dùng giai đoạn 2025 đến 2030
1. Tiêu chuẩn ISO 9001:2015 – Hệ thống quản lý chất lượng
Đây là “giấy thông hành” cơ bản nhất nhưng cũng quan trọng nhất. ISO 9001 chứng minh rằng nhà máy có khả năng cung cấp sản phẩm đạt chất lượng ổn định và đáp ứng mọi yêu cầu của khách hàng. Tại nhà máy THT Vietnam Manufacturing, mọi công đoạn từ nhập nguyên liệu đến đóng gói đều được số hóa và kiểm soát chặt chẽ theo tiêu chuẩn này.

2. Tiêu chuẩn ISO 14001:2015 – Quản lý môi trường
Trong bối cảnh biến đổi khí hậu, một doanh nghiệp hóa mỹ phẩm bền vững phải có trách nhiệm với môi trường. ISO 14001 là tiêu chuẩn đảm bảo quy trình sản xuất của nhà máy giảm thiểu tối đa rác thải, xử lý nước thải đạt chuẩn và không gây hại cho hệ sinh thái. Đây là cam kết sống còn mà THT Việt Nam luôn theo đuổi để hướng tới một tương lai xanh.

3. Tiêu chuẩn GMP (Good Manufacturing Practice)
Thực hành tốt sản xuất là tiêu chuẩn bắt buộc để đảm bảo sản phẩm được sản xuất một cách đồng nhất và kiểm soát theo đúng các tiêu chuẩn chất lượng. GMP giúp ngăn ngừa các nguy cơ ô nhiễm chéo hoặc nhầm lẫn trong quá trình sản xuất, điều cực kỳ quan trọng đối với các sản phẩm tiếp xúc trực tiếp với cơ thể như kem đánh răng hay sữa tắm.

4. Kiểm định về độ pH an toàn
Trong ngành hóa mỹ phẩm và cả nhiều ngành nghề khác, độ pH có thể nói là một chỉ số “biết nói”. Một sản phẩm chăm sóc vải vóc hay tẩy rửa gia dụng tốt phải có độ pH trung tính hoặc phù hợp với mục đích sử dụng để không làm khô da tay, không ăn mòn bề mặt thiết bị và bảo vệ cấu trúc sợi vải bền lâu.

5. Chỉ số phân hủy sinh học (Biodegradability)
Đây là tiêu chuẩn vàng của xu hướng tiêu dùng xanh. Các hoạt chất trong nước giặt hay nước lau sàn sau khi sử dụng phải có khả năng tự phân hủy trong môi trường tự nhiên, không để lại dư lượng độc hại trong nguồn nước. Đây cũng là mục tiêu mà mọi ngành nghề đều đã, đang và sẽ làm tốt hơn trong tương lai.

6. Tiêu chuẩn về nồng độ chất hoạt động bề mặt (Surfactants)
Chất hoạt động bề mặt quyết định khả năng làm sạch. Tuy nhiên, tiêu chuẩn kiểm định yêu cầu nồng độ này phải nằm trong ngưỡng an toàn, vừa đủ để bóc tách ion bẩn nhưng không quá mạnh để gây kích ứng hay làm biến chất vật liệu. Đồng thời cũng là để bảo vệ da tay cho người dùng nếu có tiếp xúc trực tiếp.

7. Kiểm soát kim loại nặng và độc tố
Mọi sản phẩm hóa mỹ phẩm uy tín đều phải đi qua bước kiểm định các kim loại nặng như chì, thủy ngân hay asen. Điều này đặc biệt quan trọng với các dòng sản phẩm chăm sóc cá nhân như bàn chải hay kem đánh răng để đảm bảo an toàn tuyệt đối cho sức khỏe người dùng lâu dài.

8. Tiêu chuẩn về vi sinh vật
Một sản phẩm chứa nhiều nước và dưỡng chất là môi trường lý tưởng cho vi khuẩn phát triển. Việc kiểm định hệ thống bảo quản để đảm bảo sản phẩm không bị nhiễm khuẩn trong suốt thời hạn sử dụng là một tiêu chuẩn bắt buộc phải tuân thủ.

9. Tiêu chuẩn về bao bì và nhựa nguyên sinh
Không chỉ là chất lỏng bên trong, bao bì cũng cần được kiểm định. Việc sử dụng nhựa nguyên sinh cao cấp không tái chế giúp đảm bảo không có các chất độc hại thôi nhiễm từ vỏ chai vào sản phẩm, bảo vệ trọn vẹn chất lượng từ nhà máy đến tay người tiêu dùng.

10. Kiểm định khả năng lưu hương bền bỉ
Mùi hương là linh hồn của sản phẩm. Tuy nhiên, tinh dầu thơm phải được kiểm định về độ an toàn khứu giác và khả năng lưu giữ hương thơm đa tầng mà không cần đến các dung môi hóa học gây hại.

THT Việt Nam: Khi tiêu chuẩn quốc tế gặp gỡ tâm huyết Việt
Tại nhà máy THT Vietnam Manufacturing, chúng tôi không coi các tiêu chuẩn kiểm định là rào cản, mà coi đó là kim chỉ nam để tạo ra sự khác biệt. Sở hữu hệ thống máy móc tự động hóa và đội ngũ kỹ sư R&D tay nghề cao, THT Việt Nam tự hào cung cấp các giải pháp OEM/ODM hàng đầu, giúp các đối tác sở hữu những nhãn hàng đạt chuẩn quốc tế ngay tại thị trường nội địa.

Việc tuân thủ nghiêm ngặt các tiêu chuẩn khắt khe nhất là cách chúng tôi khẳng định bản lĩnh của một thương hiệu Việt đồng hành cùng các vận động viên quốc gia. Chúng tôi tin rằng, một sản phẩm chỉ thực sự có giá trị khi nó được xây dựng trên nền tảng của sự minh bạch và trách nhiệm.
=> Xem thêm: Top 10 sản phẩm gia công OEM cho doanh nghiệp đạt lợi nhuận cao
Hệ sinh thái THT Việt Nam – Sự giao thoa giữa khoa học và cuộc sống
Vượt lên trên những con số và bảng biểu kiểm định khô khan, mỗi sản phẩm của THT Việt Nam là một lời cam kết về sự chỉn chu. Đó là sự tinh tế trong từng nốt hương của nước giặt Carefor, sự mạnh mẽ bóc tách vết bẩn của Siêu tẩy dầu mỡ OBAY, hay sự tỉ mỉ trong từng sợi lông chải của Dental B.

Chúng tôi không chỉ bán sản phẩm tẩy rửa hay chăm sóc cá nhân; chúng tôi trao gửi sự an tâm. Khi bạn cầm trên tay một sản phẩm của nhà THT Việt Nam, bạn đang sở hữu kết quả của hàng ngàn giờ nghiên cứu và quy trình vận hành đạt chuẩn ISO toàn cầu. Đó là cách chúng tôi nâng niu ngôi nhà của bạn, bảo vệ làn da của con trẻ và gìn giữ vẻ đẹp cho không gian sống mỗi ngày.
Tổng kết
Hiểu rõ các tiêu chuẩn kiểm định trong ngành hóa mỹ phẩm sẽ giúp bạn trở thành một người tiêu dùng thông thái hoặc một chủ doanh nghiệp nhạy bén. Đầu tư vào chất lượng chuẩn mực chính là cách ngắn nhất để xây dựng niềm tin bền vững.